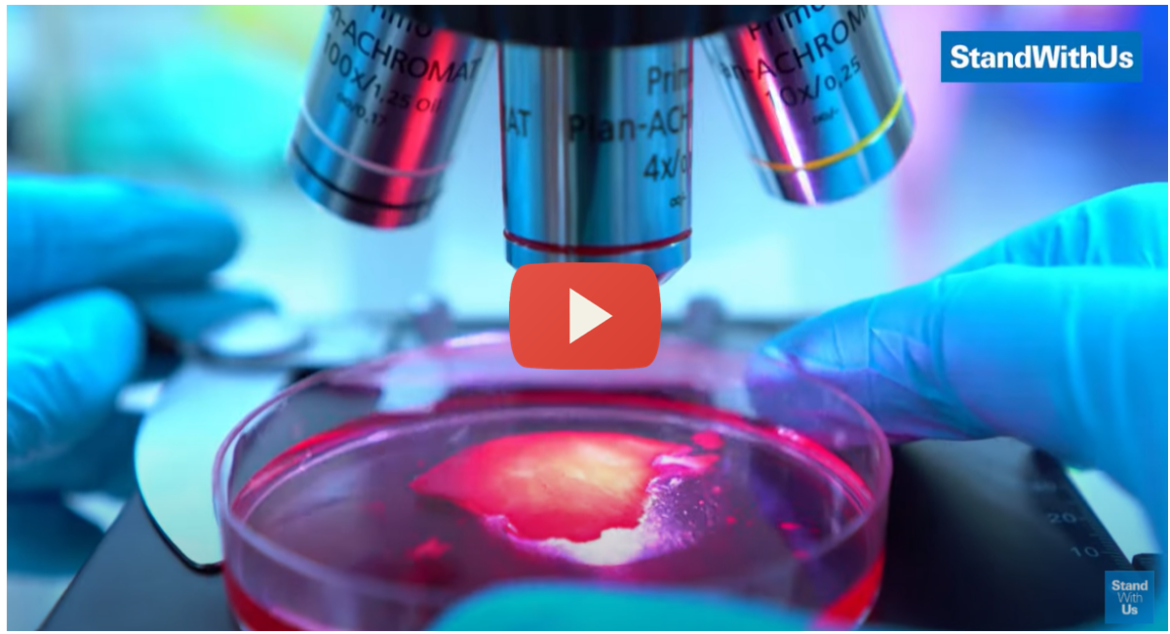

Israel isn’t a country that watches others succeed without contributing. That is why it is brilliant when it comes to medical research.
Israel and Medical Research
What Israel has done for the medical world and the world at large is remarkable. The Jewish state is a country that does not settle for mediocre. The Jewish people are always striving for more. They are always trying to reach higher and do better. And when you have such a determined people and country, the results are going to be amazing. This new medical research might hold the cure for blood cancer.
Israel, once again, has contributed something to the world that everyone should be thanking them for.
And yet, many are still attacking Israel. Too much of the world still hates Israel and spreads lies about it. Despite the fact that Israel is clearly a friendly country that has made countless contributions to the world, many people still demonize the one and only Jewish state.
Israel will continue to research and contribute to the world. It will continue to give and give, even though many give it less than nothing in return. Israel and the Jewish nation have G-d on their side. And with G-d on their side, they can accomplish miraculous things. That is obvious for anyone who knows a little bit about Jewish history and the history of the modern state of Israel.
Keep it up Israel – you may have just discovered the cure to saving the lives of millions worldwide.